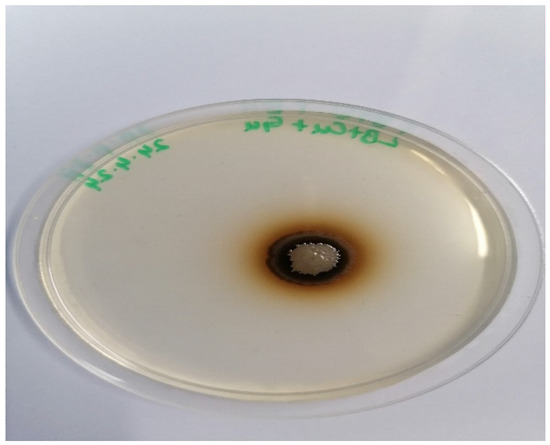

Abstract
The aim of the present research was the efficient degradation of industrial textile wastewater dyes using a very active cloned laccase enzyme. For this purpose, potent laccase-producing bacteria were isolated from soil samples collected from wastewater-replenished textile sites in Punjab, Pakistan. The laccase gene from locally isolated strain LI-81, identified as Bacillus megaterium, was cloned into vector pET21a, which was further transformed into E. coli BL21 codon plus. The optimized conditions for the increased production of laccase include fermentation in a 2% glucose, 5% yeast extract and 250 mg/L CuSO4 medium with pH 7.5; inoculation with 5% inoculum; induction with 0.1 mM IPTG at 0.5 O.D.; and incubation for 36 h at 37 °C. The crude enzyme produced was employed for the removal of commercially used textile dyes. The dyes were quickly precipitated under optimized reaction conditions. Rose bengal, brilliant green, brilliant blue G, Coomassie brilliant blue R and methylene blue were precipitated at rates of 10.69, 54.47, 84.04, 78.99 and 7.40%, respectively. The FTIR and UV–Vis spectroscopic analyses of dyes before and after confirmed the chemical changes brought about by the cloned laccase that led to the dye removal.
Keywords:
recombinant laccase; textile; dye; optimization; effluent; precipitation; Bacillus megaterium 1. Introduction
The use of textile dyes results in the discharge of toxic and carcinogenic compounds into water bodies. It is estimated that globally, over 10,000 types of textile dyes are used, with the selection of dye varying according to the type and nature of the fabric employed. Approximately 0.7 million tons of synthetic dyes are used worldwide each year [1]. During the process of dyeing, the unfixed dyes are washed away as an effluent, which increases their concentration in nearby water bodies [2]. Pakistan, being the eighth-largest exporter of textile products in Asia, requires a cost-effective and environmentally friendly method of treating textile wastewater [3].
The Scopus database has shown an overwhelming increase in interest in the treatment of textile wastewater with the help of laccase (1.10.3.2). Among others, the United States, India, South Korea, China and Mexico are actively involved in the research and application of laccase for textile wastewater treatment [4]. Researchers are introducing genetic modifications to intensify laccase activity [5]. Various manufacturers, like Amano enzyme Co., Ltd., Elgin, IL, USA; Novozymes, Bagsværd, Denmark; Season Chemicals, Taizhou, China; AB Enzymes, Darmstadt, Germany; Genecor Inc., Rochester, NY, USA; and Zytex Pvt. Ltd., Mumbai, India, are producing laccase on a commercial scale [6,7,8].
The treatment of textile wastewater with other physical and chemical methods is not efficient as it is not able to degrade all the dyes [9]. These methods sometimes convert the dyes into more harmful products [10]. In contrast, the oxidation of dyes with laccase is more promising as it acts less specifically on the aromatic ring and has a wide range of substrates. In this way, it has a high potential for the degradation of a large number of textile dyes [11]. This method can also degrade other pollutants like microplastics, pharmaceuticals and endocrine disruptors [12].
Laccase, a dioxygen oxidoreductase, is also called multicopper oxidase. It carries out the oxidation of substrates and yields water by reducing molecular oxygen. Many dimeric, oligomeric, polymeric and cross-coupling products are typically yielded by the reaction [13]. Laccase can catalyze phenolic compounds like Catechol, Resorcinol and Vanillin [14]. It also requires mediators like ABTS to catalyze inaccessible, non-phenolic compounds [15]. The diverse substrate oxidation ability of laccase is due to the copper atoms present in its catalytic region. It has four copper atoms: T1 (type 1), a blue paramagnetic copper atom; T2 (type 2), a non-blue paramagnetic copper atom; and two T3 (type 3) atoms, which are diamagnetic, spin-coupled and paired [16]. Laccase has the ability to withstand harsh pH and temperature conditions. This is due to the carbohydrate portion, which has the responsibility of providing conformational stability and resistance to proteolysis [17].
Laccase has low substrate specificity; therefore, it can act on a variety of substrates [18]. It carries out electron reduction of oxygen into water via the uptake of electrons from the substrate that causes the oxidation of the phenolic substrate [19]. The redox potential of laccase is lower than that of non-phenolic compounds, so it cannot mediate the process of oxidation alone. Thus, low-molecular-weight compounds like 2,2-azino-bis 3-ethylbenzothiaoline-6-sufonic acid (ABTS) and 1-hydroxybenzotriazole (HBT) can act as mediators to facilitate oxidation via laccase [20].
Rose bengal dye is extensively used in the textile, plastic and printing industries [21]. It has very harmful effects, which are worsened by its high solubility in water. It is therefore highly toxic for living beings [22]. Rose bengal dye is also toxic to the human corneal epithelium and causes itchiness, irritation, reddening and blistering [23]. Brilliant green dye is actively used in the wood, silk, rubber and plastic industries. It is also hazardous if it comes into contact with the human body, as prolonged and repeated exposure has the potential to cause targeted organ damage [24]. Sulfur-containing brilliant blue G is extensively used in different industries, including the textile sector, and shows reasonable stability in light, heat and an acidic environment but has a low oxidative stability, making it a good target for laccase [25]. Coomassie brilliant blue R is a triphenylmethane dye [26] that was originally developed to dye wool. Now, it is used in cases where lightfastness is not important, like hectographs, textile applications, printing inks and copying papers [27]. Methylene blue, a commonly used cationic dye for paper and leather, is very persistent, carcinogenic and mutagenic [28].
The present study was conducted to optimize the production of laccase from recombinant E. coli BL21 codon plus with the laccase gene from Bacillus megaterium and its ability to treat textile dyes. The details of the isolation and cloning of the laccase gene are provided in a previously published research paper [29]. To date, no research paper has reported the cloning and expression of laccase from Bacillus megaterium, so the present work can be helpful for other researchers in the future. In the present study, the optimization of various parameters was carried out, which significantly increased the yield.
2. Results
2.1. Isolation of Laccase-Producing Bacteria from Soil
Among various isolates obtained from the soil replenished with textile wastewater, the one with the largest zone was selected for the cloning of the laccase gene. The isolate is shown in Figure 1. The 16S rRNA sequencing results showed that the bacterial isolate was Bacillus megaterium (accession number: PQ044642).
Figure 1.
Brown zone produced by laccase-producing bacteria isolated from soil.
2.2. Cloning of Laccase Gene from Locally Isolated Bacillus megaterium
The isolated and amplified laccase gene of B. megaterium was cloned into PCR vector 2.1 and transformed into DH5α, which was confirmed by the colony PCR, as shown in Figure 2a. This gene was further sub-cloned into pET21a and transformed into E. coli BL21 codon plus. The cloning of the laccase gene was confirmed by the colony PCR, and the results are depicted in Figure 2b.

Figure 2.
(a) Colony PCR of laccase gene in vector PCR 2.1 transformed into DH5α. (b) Colony PCR of laccase gene cloned into pET21a further transformed into BL21 codon plus.
2.3. Expression of Recombinant Laccase (rILac)
It was observed that the rILac was produced intracellularly as the cell lysate showed activity against guaiacol, but the supernatant showed negligible activity (Figure 3). The total cell lysate showed 0.31 U/mL enzyme activity.

Figure 3.
Comparison of rILac activity in different fractions of LB broth culture medium.
2.4. Optimization of rILac Production
The following parameters were optimized to increase the production of rILac.
2.4.1. Effect of Medium, Fermentation Time, pH, Carbon Source and Its Concentration
Among the 10 various types of media used, it was found that LMVII, named YPD-Cu, supported the maximum production of rILac (Figure 4A). The rILac resulted in 0.51 U/mL laccase activity in this medium. The 37 °C temperature was observed to be the optimum temperature at which rILac showed activity of 0.51 U/mL (Figure 4B). The results showed 36 h of fermentation time to be the best for maximum production (Figure 4C). Here, rILac showed 0.9 U/mL enzyme activity. pH 7.5 was the best observed pH for the maximum production of rILac, showing 1.0 U/mL enzyme activity (Figure 4D).


Figure 4.
Effect of (A): medium composition (37 °C, 24 h of fermentation, 7 pH, 2% inoculum, 0.1 mM IPTG, 0.4 O.D., 100 mg/L CuSO4); (B): temperature (YPD-Cu, 24 h of fermentation, 7 pH, 2% inoculum, 0.1 mM IPTG, 0.4 O.D., 100 mg/L CuSO4); (C): fermentation time (37 °C, YPD-Cu, 7 pH, 2% inoculum, 0.1 mM IPTG, 0.4 O.D., 100 mg/L CuSO4); (D): pH (37 °C, YPD-Cu, 24 h of fermentation, 2% inoculum, 0.1 mM IPTG, 0.4 O.D., 100 mg/L CuSO4); (E): carbon source (37 °C, 24 h of fermentation, 0.2% yeast extract, 0.5% peptone, 2% inoculum, 0.1 mM IPTG, 0.4 O.D., 100 mg/L CuSO4); (F): concentration of carbon source (37 °C, YPD-Cu, 24 h of fermentation, 0.2% yeast extract, 0.5% peptone, 2% inoculum, 0.1 mM IPTG, 0.5 O.D., 100 mg/L CuSO4).
Many types of carbon sources were tested. It was found that glucose, which has already been used, was the best carbon source for the optimum production of rILac. The rIBL21 codon plus resulted in 1.0 U/mL activity, which was the maximum production among the used carbon sources. The results are depicted in Figure 4C. The varying concentrations of glucose were also analyzed to determine the optimum production of rILac. It was found that 2% glucose, which has already been used at the same concentration, resulted in the maximum production of the enzyme (Figure 4D).
2.4.2. Effect of Nitrogen Source, Its Concentration and Inoculum Size
The inorganic and organic nitrogen sources were separately assessed for their maximum recombinant yield. Among the inorganic nitrogen sources, ammonium sulfate was found to be the best, as shown in Figure 5A, while yeast extract was observed to be the best nitrogen source among the organic nitrogen sources, as depicted in Figure 5B. It was concluded that yeast extract had the maximum recombinant laccase production (1.5 U/mL) among all media by comparing the enzyme production of media with yeast extract and that with ammonium sulfate. The results showed that recombinant laccase production was dramatically increased by adding 5% yeast extract to the fermentation medium. In this case, 2.0 U/mL activity was observed, which declined upon a further increase in the yeast extract concentration (Figure 5C).


Figure 5.
Effect of (A): inorganic nitrogen source (37 °C, 24 h of fermentation, 2% glucose, 2% inoculum, 0.1 mM IPTG, 0.4 O.D., 100 mg/L CuSO4); (B): organic nitrogen source: (37 °C, 24 h of fermentation, 2% glucose, 2% inoculum, 0.1 mM IPTG, 0.4 O.D., 100 mg/L CuSO4); (C): concentration of nitrogen source (37 °C, 24 h of fermentation, 2% glucose, 2% inoculum, 0.1 mM IPTG, 0.4 O.D., 100 mg/L CuSO4); (D): inoculum size: (37 °C, 24 h of fermentation, 2% glucose, 5% yeast extract, 0.1 mM IPTG, 0.4 O.D., 100 mg/L CuSO4).
An increase in recombinant laccase production was observed by increasing the inoculum size up to 4% (2.31 U/mL). However, the further increase decreased laccase production (Figure 5D).
2.4.3. Inducer Type, Its Concentration, Induction Time and Copper Ion Concentration
By comparing the induction capacity of two inducers, lactose and IPTG, it was found that IPTG was the most suitable inducer (Figure 6A). However, the enzyme activity remained the same (2.31 U/mL) for both inducers. Various concentrations of IPTG were employed to ascertain the best concentration for producing the maximum laccase. The 0.1 mM IPTG concentration was the most effective for the efficient production of laccase (Figure 6B). The same concentration was used in the initial optimization parameters, so the enzyme activity (2.31 U/mL) remained the same.


Figure 6.
Effect of (A): inducer type (37 °C, 24 h of fermentation, 2% glucose, 5% yeast extract, 4% inoculum, 0.4 O.D., 100 mg/L CuSO4); (B): inducer concentration (37 °C, 24 h of fermentation, 2% glucose, 5% yeast extract, 4% inoculum, 0.4 O.D., 100 mg/L CuSO4); (C): optical density (37 °C, 24 h of fermentation, 2% glucose, 5% yeast extract, 4% inoculum, 0.1 mM IPTG, 100 mg/L CuSO4); (D): CuSO4 concentration (37 °C, 24 h of fermentation, 2% glucose, 5% yeast extract, 4% inoculum, 0.1 mM IPTG, 0.4 O.D.).
The most suitable induction time was determined by carrying out induction at different O.D. levels. It was found that 0.5 O.D. was the best for maximum rILac production. Inducing the culture at 0.5 O.D. caused 2.31 U/mL enzyme activity, as shown in Figure 6C. The most effective concentration of copper sulfate for the maximum rILac production was 250 mg/L, at which 2.67 U/mL recombinant laccase was produced, as shown in Figure 6D.
2.5. Dye Removal
The dyes used in the present study are actively used in the textile industry and, thus, are components of effluents. The rILac actively precipitated the dyes. The dye solutions were partially precipitated within one hour and completely precipitated within two hours, while the control mixture had the same texture, and its dye was still in a soluble state. The effect of the enzyme on the dyes is shown in Figure 7.

Figure 7.
Precipitation of textile dyes carried out by recombinant laccase.
The extent of precipitation, calculated as a percentage, is shown in Figure 8. The results show that brilliant blue G precipitated the most, followed by Coomassie brilliant blue R and then brilliant green.

Figure 8.
The precipitation percentage of dyes carried out by rILac.
FTIR and UV–Vis Spectrophotometric Analysis of the Dyes
The FTIR comparison of the dyes before and after treatment with rILac was carried out to probe the changes brought about by laccase.
A comparison of the FTIR results of rILac-treated and untreated rose bengal dye is shown in Figure 9A. The development of new peaks in the 3500 to 4000 cm−1 region shows the change in the bonding of the dye. This change in the bonding is a clear indication of the action of rILac on the dye. The transmittance dropped from 1000 to 500 cm−1, indicating the absorption of the incident light due to the high population of bonds as the vibrational energies corresponded with the incident light.

Figure 9.
FTIR analysis of the dyes before and after treatment with rILac.
In Figure 9B, the band at 3392 cm−1 is due to the N-H stretching in brilliant green. The band of C=O stretching is observed at 1641 cm−1. A clear drop in the transmittance after rILac treatment was observed at 4000–2526.74896 cm−1 and 1116.78446–500 cm−1 due to the dense precipitates that absorbed more light as the incident light corresponded with the vibrational energies of the bonds. The change in the transmittance in these bands confirms the degradation of brilliant green dye with rILac.
Figure 9C shows the changes brought about in the brilliant blue G. The peaks at 1641 cm−1 are attributed to C=O stretching, and those at 3394 cm−1 and 3433 cm−1 are due to N-H stretching. The most precipitated dye formed very dense precipitates that absorbed more light and decreased the transmittance. The increased absorption of light is caused by the high population of bonds. The comparison of the brilliant blue G dye before and after treatment showed a change in transmittance at the 4000–3741.90304 cm−1, 3568.3096–2229.7113 cm−1 and 1728.21914–500 cm−1 ranges, showing the change in bond nature.
A comparison of the rILac-treated and untreated Coomassie brilliant blue R dye is shown in Figure 9D. It shows a visible change in the transmittance due to the precipitation of the dye. A change in the peaks at 3884 and 3616 cm−1, which belongs to the O-H bond, can be observed. The change in the peak is due to the change in the nature of the bond due to the action of rILac on the dye.
Very few changes in the FTIR spectra of the methylene blue dye before and after treatment were observed (Figure 9E), as the rILac caused only slight precipitation, as mentioned earlier.
The rILac changed the composition of the dyes and the typical behavior of the dyes for the specific wavelengths. The UV–Vis spectrophotometric results show that the absorbance peaks of all the dyes were shifted from their original position, and their shapes were also altered. All the results are a clear indication of the dye removal from the solutions. Analysis shows that rILac had changed the dye composition. Rose bengal dye shows an absorption peak at 562 nm and absorbs light in the 450–650 nm wavelength region [30]. Figure 10A shows that rILac changed the optical absorbance of the dye via precipitation, which is clear from the increase in the absorbance.


Figure 10.
UV–Vis spectrophotometer analysis of the dyes before and after treatment with rILac.
Brilliant green dye typically shows an absorbance peak at 625 nm [31]. Figure 10B shows the difference between the untreated dye and the dye treated with rILac. The shift in the absorbance peak toward 650 nm and an increase in the absorbance indicates the precipitation and a compositional change brought about by rILac.
Brilliant blue G shows an absorption peak at 587 nm. The rILac changed the composition of the dye, which is evident from the change in the absorbance peak of the treated dye shown in Figure 10C. The change in the absorbance pattern can also be seen along the absorbance peak.
Coomassie brilliant blue R shows an absorption peak at 587 nm, which vanished after treatment with rILac. The absorbance pattern also changed (Figure 10D).
Methylene blue shows an absorbance peak at 664 nm. The rILac changed the shape of the absorption peak of the dye by causing the structural changes, as shown in Figure 10E. The change in the absorbance pattern can also be observed.
3. Discussion
Laccase producers were screened on the basis of the oxidation of guaiacol present in the media. The bacterial colonies that oxidized guaiacol produced a brown-colored product (biphenoquinone) in the form of a brown zone around them. The larger the zone, the higher the guaiacol production of that colony [32]. The colony that produced the largest brown zone among all was determined to be the best producer. Wang et al. [33] cloned the CotA laccase gene from Bacillus subtilis into E. coli BL21 (DE3). They also found their protein to be expressed intracellularly.
The medium YPD-Cu had all the necessary components required to support the optimum growth of E. coli, which led to more favorable production. It contained glucose, peptone, yeast extract and copper sulfate, making it a rich source of carbon, nitrogen, essential vitamins and minerals. Glucose, being a preferred source of carbon, was an ideal option for the medium [34]. Yeast extract and peptone contain many types of minerals, vitamins and amino acids, making them a good nutritional source [35]. The amino acids in the medium also help to neutralize the pH changes brought about by the glucose and metabolic processes, as the acids produced tend to shift the pH more toward an acidic level that harms the cells [36]. The addition of divalent cations in the form of copper sulfate is helpful for microbial growth, and it being a part of the active site has a direct and positive impact on laccase production [37]. Pezella et al. [38] also found that their recombinant Pichia pastoris with the laccase gene showed optimal recombinant production in the YPD medium. The maximum production at 37 °C might be due to the fact that the lac promoter is maximally active at that temperature [39]. An elevated temperature causes proteolytic damage to the proteins [40]. Basheer et al. [41] also found that recombinant E. coli with the laccase gene from Bacillus subtilis exhibited a maximum yield at 37 °C. It is observed that increasing the fermentation time up to a certain limit affects the growth pattern of the microbes. However, this effect decreases after a certain point when the available nutrients are depleted, and the concentration of toxic byproducts increases [42]. The same optimization time for laccase production was mentioned by Wang et al. [43], who cloned the laccase gene from Bacillus licheniformis into Pichia pastoris. The recombinant E.coli was found to grow optimally at 7.5 pH. This might be due to the fact that E. coli grows maximally at 6.5–7.5 pH [44]. Niladevi et al. [45] also found 7.5 pH to be the optimum for the maximum production of laccase as the metabolic machinery works optimally at that pH. The E. coli consumes glucose present in the fermentation media for the metabolic processes. The metabolic machinery produces many byproducts besides the required ones. These include acetic acid, formic acid, lactic acid, ethanol, etc., which make the media more acidic. The decline in the pH below 6 ceases the E. coli growth and causes a decline in recombinant production [46]. These results are supported by Kalyani et al. [47], who also found glucose to be the best carbon source when they expressed the laccase gene from Meiothermus ruber DSM in E. coli BL21 (DE3). The reason for the maximum laccase production by rIBL21 codon plus in the presence of glucose lies in the fact that glucose is the preferred carbon source for all micro-organisms along E. coli [48]. Kontro et al. [49] reported 2% glucose to be ideal for the production of laccase when they cloned the laccase gene from Coprinopsis cinerea into Pichia pastoris. An elevated glucose concentration has a high potential to cause catabolite repression and decrease cyclic monophosphate (cAMP), which is a starvation signal. It ultimately leads to decreased recombinant enzyme production [50]. In 2022, Umar and Ahmed [51] also reported yeast extract to be the best nitrogen source among all available organic and inorganic nitrogen sources for the maximum production of laccase. Yeast extract is a natural blend of various amino acids, purines, vitamins and glutamic acid. Therefore, it efficiently helps in the production of various complex carbohydrates, metabolites and fats. This is a possible reason for the boost in rILac production. Yeast extract has been proven to be a beneficial nitrogen source for microbial growth. Besides helping microbial growth from a nutritional point of view, it provides essential amino acids for the building of structural components. Moreover, it has been found that yeast extract helps to maintain the pH of a medium due to its basic nature, as microbial activity makes the medium acidic [36].
Lactose is the natural inducer of the T7 promoter; however, it is metabolized over time, causing the cells to revert to their uninduced state. IPTG is a synthetic inducer that is not metabolized by cells, making it a good inducer enabling cells to produce recombinant protein for a long period of time [52]. Wang and Zhao [53] observed 0.1 mM IPTG to be the best concentration for optimal induction when they cloned the CotA laccase gene in E. coli BL21 (DE3). The suitable concentration of IPTG is dependent upon various factors like the number of lac repressor molecules, lac promoter genes and the target protein. Increasing the concentration of IPTG beyond a certain point can cause the onset of an early stationary phase [54]. Moreover, it can lead to the induction of proteases that, in turn, cause the proteolytic degradation of the recombinant proteins [55]. Premature induction prevents the positive impact on recombinant enzyme production as, at that time, the cells are in the lag phase. Very late induction is also unhelpful because, after the onset of the stationary phase, the cells start dying due to nutrient depletion and toxic waste accumulation. Thus, the induction time must be carefully determined [56]. Zhang et al. [57] cloned the laccase gene from Bacillus subtilis into E. coli BL21 DE3 and found 0.1 mM IPTG to be most appropriate for expression. Copper ions, being major components of the active site of the enzyme, must be carefully optimized as they are required in a very minute concentration. The elevated levels may generate hydroxyl radicals via Fenton and Haber–Weiss reactions, which lead to lipid, protein and DNA damage [58]. Excess copper ions can also interrupt the electron transport chain, which causes an inhibition of the substrate conversion [59]. Thus, an excessive concentration of copper ions can be directly lethal to cells.
The dyes present in wastewater negatively affect the BOD (biochemical oxygen demand), COD (chemical oxygen demand), TDS (total dissolved solids), TSS (total suspended solids) and pH, making it a significant threat to the aquatic ecosystem and human beings [60]. Whenever the laccase enzyme makes contact with phenolic compounds, it leads to the formation of aryloxy radicals. These complexes spontaneously react to form precipitates, which settle in an insoluble and dense form [61]. The same behavior was exhibited by the crude rILac in the present study. This property makes rILac more suitable for the removal of textile dyes and other harmful compounds from wastewater, as these dye precipitates can be effectively removed from effluent via filtration or decantation [62]. In the present study, brilliant blue G was precipitated the most. In the past, many researchers have worked on dye treatments, but these processes were more efficient in the presence of expensive mediators like ABTS. However, in the present research, the precipitation was carried out efficiently in the absence of mediators. For example, Sharma and Leung [63] employed laccase from Sulfitobacter indolifex to decolorize many dyes like alizarin, acid red 27, Congo red, bromophenol blue, Coomassie brilliant blue R, malachite green and indigo carmine in the presence and absence of mediators like ABTS with overnight incubation. They found that in the absence of a mediator, only indigo carmine was decolorized by 90%, while other dyes exhibited precipitation of less than 40%. Loncar et al. [64] cloned the laccase gene from Bacillus amyloliquefaciens in E. coli. They studied its behavior toward the dyes. They also observed that their recombinant laccase caused the precipitation of the dye over several hours.
4. Materials and Methods
4.1. Chemicals
The analytical-grade chemicals for the present study were purchased from Merck (Darmstadt, Germany), Fluka (Buchs, Switzerland) and Sigma Chemicals Co. (St. Louis, MO, USA).
4.2. Isolation of Laccase-Producing Bacteria from Soil
The laccase-producing bacteria were isolated from the soil sample collected from the site with soil contaminated by textile dye. The production of laccase by the native strain was confirmed by the activity against 10 mM guaiacol added to the nutrient agar medium. The strain was sent for 16S rRNA sequencing for identification.
4.3. Cloning of Laccase Gene from Locally Isolated Strain
After molecular identification, the laccase gene was isolated and amplified using primers (5′-CATATGAATCCTGAGCCATTAAAAAAAAGCCATCACG-3′ forward and 5′-GGATCCTTACTCCTCCTTATAGCCTATGAAGTTAAACATGCG-3′ reverse primer) with NdeI and BamHI restriction sites. The amplified gene was cloned into PCR vector 2.1 and further transformed into E. coli DH5α. The laccase gene was further sub-cloned into pET21a by using NdeI and BamHI restriction sites. The vector bearing the laccase gene was transformed into E. coli BL21 codon plus. The whole process is explained in detail [29] in a previously published research paper.
4.4. Expression of Recombinant Laccase
The expression of recombinant laccase was analyzed by carrying out fermentation in LB broth with 50 µg/mL ampicillin and inoculation with 2% overnight inoculum of one single positive colony. When the broth attained 0.4 O.D., it was induced with 0.1 mM IPTG and 500 mM CuSO4. The cells from the overnight grown culture were separated from the supernatant via centrifugation at 6000 RPM for 20 min to determine the enzyme activity in each fraction. The pellet was sonicated via resuspension in 500 mM Tris-Cl pH 7 buffer. The cells were sonicated for 30 min by setting the sonication cycle to 30 s burst and 30 s off. The cell lysate was obtained after centrifugation for enzyme activity analysis. The enzyme activity was determined in both the supernatant and cell lysate by following the protocol of Peter et al. [65]. The reaction mixture contained 50 mM guaiacol, 100 mM sodium acetate buffer (pH 5.5) and the enzyme. The change in O.D. was observed at 530 nm. The enzyme activity of laccase is defined as the amount of enzyme required to catalyze one micromole of substrate per minute [66]. The formula for the determination of enzyme activity is provided below.
where Vt = final volume of reaction mixture (mL); Vs = sample volume (mL); ε = extinction co-efficient of guaiacol (62.5).
4.5. Optimization of Laccase Production from Recombinant E. coli
Various fermentation parameters were extensively optimized to increase the rILac production. These parameters included medium (LMI: glucose 40 g/L, glycerol 7 g/L, L-histidine 0.50 g/L, NaNO3 1.80 g/L, CuSO4 0.10 g/L, NaCl 1.80 g/L, KCl 0.50 g/L, CaCl2·H2O 0.50 g/L, FeSO4·7H2O 0.05 g/L, KH2PO4 1.00, MgSO4·7H2O 0.50 g/L; LMII: glucose 10.0 g/L, peptone 3.0 g/L, KH2PO4 0.6 g/L, K2HPO4 0.4 g/L, ZnSO4 0.001 g/L, FeSO4 0.0005 g/L, MnSO4 0.05 g/L, MgSO4 0.5 g/L, CuSO4 0.01 g/L; LMIII: peptone 3 g/L, glucose 10 g/L, KH2PO4 0.6 g/L, K2HPO4 0.4 g/L, ZnSO4 0.001 g/L, FeSO4 0.0005 g/L, MnSO4 0.05 g/L, MgSO4 0.5 g/L; LMIV: potassium hydrogen phthalate 0.04 g/L, NaNO3 2.6 g/L, K2HPO4 0.4 g/L, KH2PO4 0.6 g/L, MgSO4·7H2O 0.5 g/L, NaCl 0.5 g/L; LMV: glucose 10.0 g/L, Asparagine 0.50 g/L, yeast extract 0.50 g/L, K2HPO4 0.50, MgSO4·7H2O 1.00, FeSO4·7H2O 0.01; LMVI (Terrific broth): bacto-tryptone 12 g/L, bacto-yeast 24 g/L, glycerol 4 mL, (0.17 M KH2PO4 + 0.72 M K2HPO4 = 100 mL); LMVII (YPD-Cu medium): glucose 20 g/L, peptone 5 g/L, yeast extract 2 g/L, CuSO4 100 mg/L; LMVIII (LB broth): yeast extract 5.0 g/L (w/v), tryptone 10.0 g/L (w/v), NaCl 10.0 g/L (w/v); LMIX (Super broth): tryptone-bacto 32 g/L, yeast extract 20 g/L, NaCl 5 g/L; LMX (TYGPN medium): tryptone 20 g/L, yeast extract 10 g/L, glycerol 80% 10 mL/L, Na2HPO4 5 g/L, KNO3 10 g/L), temperature (31, 33, 35, 37, 39 and 41 °C), fermentation time (12–72 h with a 6 h gap), pH (5.0, 5.5, 6.0, 6.5, 7.0, 7.5, 8.0, 8.5 and 9.0), carbon source (sucrose, fructose, glucose, maltose, mannitol, starch, lactose, dextrose, glycerol, galactose and saccharose) and concentration. The inorganic (ammonium sulfate, sodium citrate, calcium nitrate, ammonium chloride, ammonium nitrate and sodium nitrate) and organic (peptone, yeast extract, tryptone, urea, glycine, tryptophan and skimmed milk) nitrogen sources and their optimum concentrations were also determined. The inoculum size (1–5 mL), inducer type, inducer concentration, induction time (0.4, 0.5, 0.6, 0.7 and 0.8 O.D.) and copper ion concentration were also optimized.
4.6. Dye Removal
The activity of the produced rILac was assessed to determine its efficiency against solutions of various dyes. The reaction mixture was prepared with three components, namely, sodium acetate buffer, rILac and dye. The various dyes employed for this purpose included rose bengal, brilliant green, brilliant blue G, Coomassie brilliant blue R and methylene blue, which are actively used in the textile industry. The final concentration of these dyes was set to 100 mg/L by dissolving them in distilled water, and the final concentration of the rILac in the reaction mixture was 1 U/mL. On the other hand, the control mixture contained only sodium acetate buffer (pH 5.5) and dye. The effect of the recombinant enzyme on the dye was studied under standard assay conditions [67]. The change in O.D. for the dyes rose bengal, brilliant green, brilliant blue G, Coomassie brilliant blue R and methylene blue was studied at 562, 625, 587, 587 and 664 nm, respectively. The precipitation percentage of dye was calculated using the following formula [68].
O.D. initial = O.D. before precipitation
O.D. final = O.D. after precipitation
FTIR and UV–Vis Spectrophotometric Analysis of the Dyes
The precipitated dyes were analyzed with FTIR spectroscopy for changes in the chemical structure of the dyes before and after treatment with rILac.
The extent of precipitation was studied in detail via UV–Vis spectrophotometric analysis of the dyes before and after treatment with the dyes. The rose bengal dye exhibits an absorbance peak at 562 nm; therefore, the changes in the absorbance pattern before and after treatment were studied in the 450–650 nm region [30]. Brilliant green dye exhibits an absorbance peak at 625 nm. Therefore, the absorbance pattern was studied at 400–700 nm [69]. Brilliant blue G, Coomassie brilliant blue R and methylene blue show absorbance peaks at 587 nm [70,71] and 664 nm [63].
5. Conclusions
The laccase gene cloned from B. megaterium resulted in a successful clone, the production of which was optimized. The optimized recombinant enzyme very efficiently removed textile dyes from the water via precipitation. This useful application of rILac can be further studied and optimized in the future, given the global need for sustainable enzymatic treatment of wastewater. In this way, environmental pollution, which is a main concern due to its potent health hazards, can be overcome.
Author Contributions
Conceptualization, I.u.H., M.N.A. and Z.M.; Methodology, Z.M., A.u.R. and A.N.; Formal analysis, I.u.H.; Investigation, Z.M. and A.u.R.; Resources, I.u.H.; Data curation, Z.M. and A.H.A.; Writing—original draft preparation, Z.M.; Writing—review and editing, A.N. and A.A.A.; Visualization, A.H.A. and A.N.; Supervision, I.u.H.; Project administration, I.u.H.; Funding acquisition; I.u.H. All authors have read and agreed to the published version of the manuscript.
Funding
This research was funded by the Pakistan Academy of Sciences, Islamabad, Pakistan, grant number 94/PAS.
Institutional Review Board Statement
Not applicable.
Informed Consent Statement
Not applicable.
Data Availability Statement
Data are contained within the article.
Acknowledgments
We are thankful to the Office of Research Innovation and Commercialization (ORIC), GC University Lahore, Pakistan, for the partial funding and support. We also appreciate the help and guidance provided by SBS University of the Punjab, Lahore, Pakistan. Moreover, we are grateful to CASP and the Central Lab of GC University Lahore, Pakistan, for their technical support regarding FTIR and UV–Vis spectrometry.
Conflicts of Interest
The authors declare no conflicts of interest. The funders had no role in the design of the study; in the collection, analyses, or interpretation of data; in the writing of the manuscript; or in the decision to publish the results.
References
- Sriram, G.; Bendre, A.; Mariappan, E.; Altalhi, T.; Kigga, M.; Ching, Y.C.; Jung, H.Y.; Bhaduri, B.; Kurkuri, M. Recent trends in the application of metal-organic frameworks (MOFs) for the removal of toxic dyes and their removal mechanism-a review. Sustain. Mater. Technol. 2022, 31, e00378. [Google Scholar] [CrossRef]
- Ahmed, M.A.; Mohamed, A.A. A systematic review of layered double hydroxide-based materials for environmental remediation of heavy metals and dye pollutants. Inorg. Chem. Commun. 2023, 148, 110325. [Google Scholar] [CrossRef]
- Munir, S.R. Domestic Lobbying for External Change: Textile Sector and Pakistan’s Entry into Generalised System of Preferences Plus. J. Asian Afr. Stud. 2023, 00219096231192314. [Google Scholar] [CrossRef]
- Puspita, K.; Chiari, W.; Abdulmadjid, S.N.; Idroes, R.; Iqhrammullah, M. Four decades of laccase research for wastewater treatment: Insights from bibliometric analysis. Int. J. Environ. Res. Public Health 2022, 20, 308. [Google Scholar] [CrossRef]
- Yadav, A.; Khera, K.; Mehrotra, R.; Verma, P.; Yadav, D.; Kudanga, T. Laccase engineering: Tailoring laccases for effective and efficient catalysis. In Bacterial Laccases; Academic Press: Cambridge, MA, USA, 2024; pp. 103–124. [Google Scholar]
- Zerva, A.; Simić, S.; Topakas, E.; Nikodinovic-Runic, J. Applications of microbial laccases: Patent review of the past decade (2009–2019). Catalysts 2019, 9, 1023. [Google Scholar] [CrossRef]
- De Gonzalo, G.; Lavandera, I. Enzymatic Commercial Sources. In Biocatalysis for Practitioners: Techniques, Reactions and Applications; Wiley: Hoboken, NJ, USA, 2021; pp. 467–485. [Google Scholar]
- Osma, J.F.; Toca-Herrera, J.L.; Rodríguez-Couto, S. Uses of laccases in the food industry. Enzym. Res. 2010, 2010, 918761. [Google Scholar] [CrossRef]
- Sharma, P.; Qanungo, K. Challenges in effluents treatment containing dyes. Adv. Res. Text. Eng. 2022, 7, 1075. [Google Scholar]
- Kolya, H.; Kang, C.W. Toxicity of Metal Oxides, Dyes, and Dissolved Organic Matter in Water: Implications for the Environment and Human Health. Toxics 2024, 12, 111. [Google Scholar] [CrossRef]
- Magalhães, F.F.; Pereira, A.F.; Cristóvão, R.O.; Barros, R.A.; Faria, J.L.; Silva, C.G.; Freire, M.G.; Tavares, A.P. Recent Developments and Challenges in the Application of Fungal Laccase for the Biodegradation of Textile Dye Pollutants. Mini-Rev. Org. Chem. 2024, 21, 609–632. [Google Scholar] [CrossRef]
- Kolak, S.; Birhanlı, E.; Boran, F.; Bakar, B.; Ulu, A.; Yeşilada, Ö.; Ateş, B. Tailor-made novel electrospun polycaprolactone/polyethyleneimine fiber membranes for laccase immobilization: An all-in-one material to biodegrade textile dyes and phenolic compounds. Chemosphere 2023, 313, 137478. [Google Scholar] [CrossRef]
- Dos Santos, P.M.; Baruque, J.R.; de Souza Lira, R.K.; Leite, S.G.; Do Nascimento, R.P.; Borges, C.P.; Wojcieszak, R.; Itabaiana, I., Jr. Corn cob as a green support for laccase immobilization—Application on decolorization of Remazol Brilliant Blue R. Int. J. Mol. Sci. 2022, 23, 9363. [Google Scholar] [CrossRef] [PubMed]
- Sun, X.; Bai, R.; Zhang, Y.; Wang, Q.; Fan, X.; Yuan, J.; Cui, L.; Wang, P. Laccase-catalyzed oxidative polymerization of phenolic compounds. Appl. Biochem. Biotechnol. 2013, 171, 1673–1680. [Google Scholar] [CrossRef] [PubMed]
- Munk, L.; Andersen, M.L.; Meyer, A.S. Influence of mediators on laccase catalyzed radical formation in lignin. Enzym. Microb. Technol. 2018, 116, 48–56. [Google Scholar] [CrossRef] [PubMed]
- Gavryushov, S.; Kuzmich, N.N.; Polyakov, K.M. Quantum Mechanical Study of Oxygen Ligands Protonation for the Stable States of the Laccase Active Site. Int. J. Mol. Sci. 2023, 24, 2990. [Google Scholar] [CrossRef]
- Jeyabalan, J.; Veluchamy, A.; Kumar, A.; Chandrasekar, R.; Narayanasamy, S. A review on the laccase assisted decolourization of dyes: Recent trends and research progress. J. Taiwan Inst. Chem. Eng. 2023, 151, 105081. [Google Scholar] [CrossRef]
- d‘Acunzo, F.; Galli, C.; Masci, B. Oxidation of phenols by laccase and laccase-mediator systems: Solubility and steric issues. Eur. J. Biochem. 2002, 269, 5330–5335. [Google Scholar] [CrossRef] [PubMed]
- Bibi, I.; Bhatti, H.N.; Asgher, M. Comparative study of natural and synthetic phenolic compounds as efficient laccase mediators for the transformation of cationic dye. Biochem. Eng. J. 2011, 56, 225–231. [Google Scholar] [CrossRef]
- Gu, Y.; Yuan, L.; Jia, L.; Xue, P.; Yao, H. Recent developments of a co-immobilized laccase–mediator system: A review. RSC Adv. 2021, 11, 29498–29506. [Google Scholar] [CrossRef]
- Murugadoss, G.; Kumar, D.D.; Kumar, M.R.; Venkatesh, N.; Sakthivel, P. Silver decorated CeO2 nanoparticles for rapid photocatalytic degradation of textile rose bengal dye. Sci. Rep. 2021, 11, 1080. [Google Scholar] [CrossRef]
- Lops, C.; Ancona, A.; Di Cesare, K.; Dumontel, B.; Garino, N.; Canavese, G.; Hérnandez, S.; Cauda, V. Sonophotocatalytic degradation mechanisms of Rhodamine B dye via radicals generation by micro-and nano-particles of ZnO. Appl. Catal. Environ. 2019, 243, 629–640. [Google Scholar] [CrossRef]
- Vinuth, M.; Naik, H.B.; Vinoda, B.M.; Pradeepa, S.M.; Kumar, G.A.; Sekhar, K.C. Rapid removal of hazardous Rose Bengal dye using Fe (III)–Montmorillonite as an effective adsorbent in aqueous solution. J. Environ. Anal. Toxicol. 2016, 6, 1000355. [Google Scholar]
- Kismir, Y.; Aroguz, A.Z. Adsorption characteristics of the hazardous dye Brilliant Green on Saklıkent mud. Chem. Eng. J. 2011, 172, 199–206. [Google Scholar] [CrossRef]
- Ferreira, L.G.; Faria, R.X.; Ferreira, N.C.; Soares-Bezerra, R.J. Brilliant Blue Dyes in daily food: How could purinergic system be affected? Int. J. Food Sci. 2016, 2016, 7548498. [Google Scholar] [CrossRef]
- Paz, A.; Carballo, J.; Pérez, M.J.; Domínguez, J.M. Biological treatment of model dyes and textile wastewaters. Chemosphere 2017, 181, 168–177. [Google Scholar] [CrossRef]
- Tahir, H.; Alam, U. Lignocellulosic: Non-conventional low cost biosorbent for the elution of coomassie brilliant blue (R-250). Int. J. Chem. 2014, 6, 56. [Google Scholar] [CrossRef]
- Oladoye, P.O.; Ajiboye, T.O.; Omotola, E.O.; Oyewola, O.J. Methylene blue dye: Toxicity and potential elimination technology from wastewater. Results Eng. 2022, 16, 100678. [Google Scholar] [CrossRef]
- Mustafa, Z.; Haq, I.U.; Aftab, M.N.; Nawaz, A.; Rehman, A.U.; Akram, F. Cloning of Bacillus megaterium laccase gene isolated from textile waste water replenished soil. Pak. J. Bot. 2024, 56, 783–789. [Google Scholar] [CrossRef]
- Beedri, N.I.; Sayyed, S.A.; Jadkar, S.R.; Pathan, H.M. Rose Bengal sensitized niobium pentaoxide photoanode for dye sensitized solar cell application. AIP Conf. Proc. 2017, 1832, 040022. [Google Scholar]
- Kaur, S.; Sharma, S.; Umar, A.; Singh, S.; Mehta, S.K.; Kansal, S.K. Solar light driven enhanced photocatalytic degradation of brilliant green dye based on ZnS quantum dots. Superlattices Microstruct. 2017, 103, 365–375. [Google Scholar] [CrossRef]
- Devasia, S.; Nair, A.J. Screening of potent laccase producing organisms based on the oxidation pattern of different phenolic substrates. Int. J. Cur. Microbiol. App. Sci. 2016, 5, 127–137. [Google Scholar] [CrossRef][Green Version]
- Wang, C.; Cui, D.; Lu, L.; Zhang, N.; Yang, H.; Zhao, M.; Dai, S. Cloning and characterization of CotA laccase from Bacillus subtilis WD23 decoloring dyes. Ann. Microbiol. 2016, 66, 461–467. [Google Scholar] [CrossRef]
- Rosano, G.L.; Morales, E.S.; Ceccarelli, E.A. New tools for recombinant protein production in Escherichia coli: A 5-year update. Protein Sci. 2019, 28, 1412–1422. [Google Scholar] [CrossRef] [PubMed]
- Li, M.; Liao, X.; Zhang, D.; Du, G.; Chen, J. Yeast Extract Promotes Cell Growth and Induces Production of Polyvinyl Alcohol-Degrading Enzymes. Enzym. Res. 2011, 2011, 179819. [Google Scholar] [CrossRef] [PubMed]
- Studier, F.W. Protein production by auto-induction in high-density shaking cultures. Protein Expr. Purif. 2005, 41, 207–234. [Google Scholar] [CrossRef] [PubMed]
- Rosano, G.L.; Ceccarelli, E.A. Recombinant protein expression in Escherichia coli: Advances and challenges. Front. Microbiol. 2014, 5, 172. [Google Scholar] [CrossRef] [PubMed]
- Pezzella, C.; Giacobelli, V.G.; Lettera, V.; Olivieri, G.; Cicatiello, P.; Sannia, G.; Piscitelli, A. A step forward in laccase exploitation: Recombinant production and evaluation of techno-economic feasibility of the process. J. Biotechnol. 2017, 259, 175–181. [Google Scholar] [CrossRef]
- Itakura, K.; Tadaaki, H.; Crea, R.; Riggs, A.D.; Heyneker, H.L.; Bolivar, F.; Boyer, H.W. Expression in Escherichia coli of a chemically synthesized gene for the hormone somatostatin. 1977. Biotechnol. (Read. Mass.) 1992, 24, 84–91. [Google Scholar]
- Chesshyre, J.A.; Hipkiss, A.R. Low temperatures stabilize interferon α-2 against proteolysis in Methylophilus methylotrophus and Escherichia coli. Appl. Microbiol. Biotechnol. 1989, 31, 158–162. [Google Scholar] [CrossRef]
- Basheer, S.; Rashid, N.; Akram, M.S.; Akhtar, M. A highly stable laccase from Bacillus subtilis strain R5: Gene cloning and characterization. Biosci. Biotechnol. Biochem. 2019, 83, 436–445. [Google Scholar] [CrossRef]
- Maftukhah, S.; Abdullah, A. Cellulase enzyme production from rice straw using solid state fermentation and fungi Aspergillus niger ITBCC L74. MATEC Web Conf. 2018, 156, 01010. [Google Scholar] [CrossRef][Green Version]
- Wang, J.; Lu, L.; Feng, F. Combined strategies for improving production of a thermo-alkali stable laccase in Pichia pastoris. Electron. J. Biotechnol. 2017, 28, 7–13. [Google Scholar] [CrossRef]
- Wang, H.; Wang, F.; Wang, W.; Yao, X.; Wei, D.; Cheng, H.; Deng, Z. Improving the expression of recombinant proteins in E. coli BL21 (DE3) under acetate stress: An alkaline pH shift approach. PLoS ONE 2014, 9, e112777. [Google Scholar] [CrossRef] [PubMed]
- Niladevi, K.N.; Sukumaran, R.K.; Jacob, N.; Anisha, G.S.; Prema, P. Optimization of laccase production from a novel strain—Streptomyces psammoticus using response surface methodology. Microbiol. Res. 2009, 164, 105–113. [Google Scholar] [CrossRef] [PubMed]
- Russell, J.B. Another explanation for the toxicity of fermentation acids at low pH: Anion accumulation versus uncoupling. J. Appl. Bacteriol. 1992, 73, 363–370. [Google Scholar] [CrossRef]
- Kalyani, D.C.; Munk, L.; Mikkelsen, J.D.; Meyer, A.S. Molecular and biochemical characterization of a new thermostable bacterial laccase from Meiothermus ruber DSM 1279. RSC Adv. 2016, 6, 3910–3918. [Google Scholar] [CrossRef]
- Bren, A.; Park, J.O.; Towbin, B.D.; Dekel, E.; Rabinowitz, J.D.; Alon, U. Glucose becomes one of the worst carbon sources for E. coli on poor nitrogen sources due to suboptimal levels of cAMP. Sci. Rep. 2016, 6, 24834. [Google Scholar] [CrossRef]
- Kontro, J.; Lyra, C.; Koponen, M.; Kuuskeri, J.; Kähkönen, M.A.; Wallenius, J.; Wan, X.; Sipilä, J.; Mäkelä, M.R.; Nousiainen, P.; et al. Production of recombinant laccase from Coprinopsis cinerea and its effect in mediator promoted lignin oxidation at neutral pH. Front. Bioeng. Biotechnol. 2021, 9, 767139. [Google Scholar] [CrossRef]
- Brown, W.; Ralston, A.; Shaw, K. Positive transcription control: The glucose effect. Nat. Educ. 2008, 1, 202. [Google Scholar]
- Umar, A.; Ahmed, S. Optimization, purification and characterization of laccase from Ganoderma leucocontextum along with its phylogenetic relationship. Sci. Rep. 2022, 12, 2416. [Google Scholar] [CrossRef]
- Hausjell, J.; Kutscha, R.; Gesson, J.D.; Reinisch, D.; Spadiut, O. The effects of lactose induction on a plasmid-free E. coli T7 expression system. Bioengineering 2020, 7, 8. [Google Scholar] [CrossRef]
- Wang, T.N.; Zhao, M. A simple strategy for extracellular production of CotA laccase in Escherichia coli and decolorization of simulated textile effluent by recombinant laccase. Appl. Microbiol. Biotechnol. 2017, 101, 685–696. [Google Scholar] [CrossRef] [PubMed]
- Glick, B.R. Metabolic load and heterologous gene expression. Biotechnol. Adv. 1995, 13, 247–261. [Google Scholar] [CrossRef] [PubMed]
- Rizkia, P.R.; Silaban, S.; Hasan, K.; Kamara, D.S.; Subroto, T.; Soemitro, S.; Maksum, I.P. Effect of Isopropyl-β-D-thiogalactopyranoside concentration on prethrombin-2 recombinan gene expression in Escherichia coli ER2566. Procedia Chem. 2015, 17, 118–124. [Google Scholar] [CrossRef]
- Martin, K. A Deep Dive Into Induction with IPTG; Gold Biotechnology: St. Louis, MO, USA, 2020. [Google Scholar]
- Zhang, Y.; Dong, W.; Lv, Z.; Liu, J.; Zhang, W.; Zhou, J.; Xin, F.; Ma, J.; Jiang, M. Surface display of bacterial laccase CotA on Escherichia coli cells and its application in industrial dye decolorization. Mol. Biotechnol. 2018, 60, 681–689. [Google Scholar] [CrossRef]
- Ramos-Zúñiga, J.; Bruna, N.; Pérez-Donoso, J.M. Toxicity mechanisms of copper nanoparticles and copper surfaces on bacterial cells and viruses. Int. J. Mol. Sci. 2023, 24, 10503. [Google Scholar] [CrossRef]
- Navas, L.E.; Carballo, R.; Levin, L.; Berretta, M.F. Fast decolorization of azo dyes in alkaline solutions by a thermostable metal-tolerant bacterial laccase and proposed degradation pathways. Extremophiles 2020, 24, 705–719. [Google Scholar] [CrossRef]
- Manzoor, J.; Sharma, M. Impact of textile dyes on human health and environment. In Impact of Textile Dyes on Public Health and the Environment; IGI Global: Hershey, PA, USA, 2020; pp. 162–169. [Google Scholar]
- Strong, P.J.; Claus, H. Laccase: A review of its past and its future in bioremediation. Crit. Rev. Environ. Sci. Technol. 2011, 41, 373–434. [Google Scholar] [CrossRef]
- Ardila-Leal, L.D.; Poutou-Piñales, R.A.; Pedroza-Rodríguez, A.M.; Quevedo-Hidalgo, B.E. A brief history of colour, the environmental impact of synthetic dyes and removal by using laccases. Molecules 2021, 26, 3813. [Google Scholar] [CrossRef]
- Sharma, N.; Leung, I.K. Novel thermophilic bacterial laccase for the degradation of aromatic organic pollutants. Front. Chem. 2021, 9, 711345. [Google Scholar] [CrossRef]
- Lončar, N.; Božić, N.; Lopez-Santin, J.; Vujčić, Z. Bacillus amyloliquefaciens laccase—From soil bacteria to recombinant enzyme for wastewater decolorization. Bioresour. Technol. 2013, 147, 177–183. [Google Scholar] [CrossRef]
- Peter, J.K.; Kumar, P.V. Production optimization and partial purification of laccases from bacterial consortium. Int. J. Eng. Res. 2014, 3, 458–465. [Google Scholar]
- Góralczyk-Bińkowska, A.; Jasińska, A.; Długoński, A.; Płociński, P.; Długoński, J. Laccase activity of the ascomycete fungus Nectriella pironii and innovative strategies for its production on leaf litter of an urban park. PLoS ONE 2020, 15, 0231453. [Google Scholar]
- Khehra, M.S.; Saini, H.S.; Sharma, D.K.; Chadha, B.S.; Chimni, S.S. Decolorization of various azo dyes by bacterial consortium. Dyes Pigments 2005, 67, 55–61. [Google Scholar] [CrossRef]
- Ashour, S.; Abo-Ghalia, H. Optimization of environmental parameters on the decolorization of Reactive Brilliant Blue dye by yeast isolates from textile effluent. J. Sci. Res. Sci. 2015, 32 Pt 1, 122–146. [Google Scholar]
- Green, F.J. The Sigma-Aldrich Handbook of Stains, Dyes, and Indicators; Sigma-Aldrich: St. Louis, MO, USA, 1990. [Google Scholar]
- Dong, X.; Zhou, J.; Liu, Y. Peptone-induced biodecolorization of reactive brilliant blue (KN-R) by Rhodocyclus gelatinosus XL-1. Proc. Biochem. 2003, 39, 89–94. [Google Scholar] [CrossRef]
- Liu, S.T.; Huang, J.; Ye, Y.; Zhang, A.B.; Pan, L.; Chen, X.G. Microwave enhanced Fenton process for the removal of methylene blue from aqueous solution. Chem. Eng. J. 2013, 215, 586–590. [Google Scholar] [CrossRef]
Disclaimer/Publisher’s Note: The statements, opinions and data contained in all publications are solely those of the individual author(s) and contributor(s) and not of MDPI and/or the editor(s). MDPI and/or the editor(s) disclaim responsibility for any injury to people or property resulting from any ideas, methods, instructions or products referred to in the content. |
© 2024 by the authors. Licensee MDPI, Basel, Switzerland. This article is an open access article distributed under the terms and conditions of the Creative Commons Attribution (CC BY) license (https://creativecommons.org/licenses/by/4.0/).














